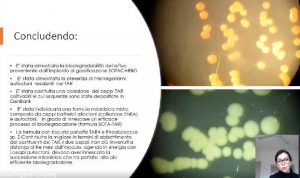

È un tema sempre dibattuto quello della convivenza possibile tra lo sfruttamento delle risorse e la salvaguardia dell’ambiente. La scienza e la ricerca provano quotidianamente a trovare delle soluzioni. Ad esempio, per l’abbattimento degli idrocarburi si fa ricorso agli studi di fattibilità per l’applicazione di una bonifica biologica o al trattamento biologico applicato ai reflui di gassificazione di biomasse legnose.
Va in questa direzione il progetto Tecnologie e strumenti di caratterizzazione e gestione avanzata dell’ambiente (Testare), tra i 35 progetti promossi da Sardegna ricerche nell’ambito del più ampio programma Azioni cluster top-down. L’iniziativa è finanziata con il Por fesr Sardegna 2014-2020 e condotta dal dipartimento di Scienze chimiche e geologiche dell’università di Cagliari (Dscg) insieme a Crs4, Sotacarbo, ente di ricerca partecipato da Enea e regione Sardegna e 15 aziende del territorio.
Il 10 febbraio scorso sono stati presentati i risultati delle iniziative promosse sul territorio. Le aziende hanno testato una serie di kit per valutare gli impatti delle loro attività su suoli, acque e aria. Alcune hanno adoperato tecnologie per valorizzare le scorie, altre hanno eliminato gli inquinanti con soluzioni di recupero, bonifica e risanamento allo stato dell’arte. Sono state applicate anche tecniche geofisiche, non invasive, per la caratterizzazione delle proprietà del sottosuolo in siti con problemi di contaminazione con lo scopo di definire la presenza di sostanze inquinanti, lo stato di degradazione e le proprietà idrauliche.
Per ciò che riguarda il trattamento biologico, usato in serie con quello chimico-fisico, ha spiegato Alessandro Orsini di Sotacarbo, tra i relatori dell’evento, c’è la possibilità di “catturare e riutilizzare l’anidride carbonica. Gli impianti di gassificazione delle biomasse sono principalmente di natura legnosa e producono materiale di recupero”. Un modo per implementare i principi di economia circolare sul territorio.
Nella ex miniera di Masua, nel sud della Sardegna, si è dovuto affrontare il problema della “contaminazione da idrocarburi che superava i valori del 2010 nel sito minerario, già destinato a bonifica specifica per i metalli”, spiega Anna Rosa Sprocati dell’Enea. Si è dovuto verificare la fattibilità di un risanamento e individuare i microrganismi più idonei a contrastare l’effetto negativo di cadmio, mercurio, piombo e zinco. In questo caso si parla di biorisanamento, “unico processo che aiuta a trattare i composti”, ma che “non ha dato valori eccezionali”. L’obiettivo, resta, per la scienza e la ricerca quello di proseguire nella ricerca per trovare le soluzioni più idonee, in base alla disponibilità tecnologica e alla peculiarità del territorio.
Per ricevere quotidianamente i nostri aggiornamenti su energia e transizione ecologica, basta iscriversi alla nostra newsletter gratuita
e riproduzione totale o parziale in qualunque formato degli articoli presenti sul sito.